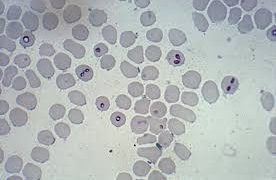

家畜害虫
家畜害虫 マダニ亜目(Ixodides) ~ マダニ(hard ticks)
マダニ亜目に属するダニ類は哺乳動物、鳥類、爬虫類などに寄生します。しかし、牛、馬などを放牧した場合に多数マダニ類の寄生をうけ、これら家畜は栄養障害を起こし、貧血したり、死亡することもあります。このようにマダニは、家畜害虫のうちもっとも重要な...
 家畜害虫
家畜害虫  ダニ類
ダニ類  ウマ(馬)の病気
ウマ(馬)の病気  ウマ(馬)の病気
ウマ(馬)の病気  ウマ(馬)の病気
ウマ(馬)の病気 ウシ(牛)の病気
ウシ(牛)の病気  ウシ(牛)の病気
ウシ(牛)の病気  ヤギ(山羊)の病気
ヤギ(山羊)の病気  犬
犬  その他
その他